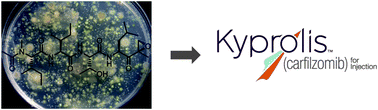
Graphical abstract: From epoxomicin to carfilzomib: chemistry, biology, and medical outcomes

Covering: 1992 to 2012
The initial enthusiasm following the discovery of a pharmacologically active natural product is often fleeting due to the poor prospects for its ultimate clinical application. Despite this, the ever-changing landscape of modern biology has a constant need for molecular probes that can aid in our understanding of biological processes. After its initial discovery by Bristol-Myers Squibb as a microbial anti-tumor natural product, epoxomicin was deemed unfit for development due to its peptide structure and potentially labile epoxyketone pharmacophore. Despite its drawbacks, epoxomicin's pharmacophore was found to provide unprecedented selectivity for the proteasome. Epoxomicin also served as a scaffold for the generation of a synthetic tetrapeptide epoxyketone with improved activity, YU-101, which became the parent lead compound of carfilzomib (Kyprolis™), the recently approved therapeutic agent for multiple myeloma. In this era of rational drug design and high-throughput screening, the prospects for turning an active natural product into an approved therapy are often slim. However, by understanding the journey that began with the discovery of epoxomicin and ended with the successful use of carfilzomib in the clinic, we may find new insights into the keys for success in natural product-based drug discovery.

You have access to this article
 Please wait while we load your content...
Something went wrong. Try again?
Please wait while we load your content...
Something went wrong. Try again?

Please wait while we load your content...
Please wait while we load your content...